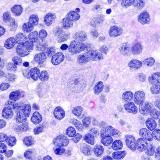
neurofun🧠

«Здоровье & Медицина» – результаты поиска

Allpedio (Dr_lgoryaka и Docbelol)
Игорь Кривов - педиатр @Dr_Igoryaka Белянкина Ольга - аллерголог @Docbelol 🏥 Прием в клиниках Docdeti и Чайка ☎️ Консультации онлайн Поможем разобраться в педиатрии и аллергологии.


Dr.mikitin
Канал о Пластической Хирургии, Красоте и трансформации внешности. Если хотели бы записаться на бесплатную консультацию - напишите прямо сейчас администратору чата по ссылке @mikitindr_bot Я в МАКС — https://max.ru/dr_mikitin



INBI
🌏 Центр мировых традиций и практик развития человека INBI World. ⏳Клуб основан в 1987 году 📍Место силы в центре Москвы 🌐 Сайт: inbi.ru Основные направления: - Тайцзи-цюань, цигун - Женские даосские практики - Практики развития мозга - Капоэйра и др.


#ЧтоТоНовенькое
О здоровом питании детей в семье и школе Чат-бот для обратной связи: @ctnovoe_bot

Доктор Эрлихман
Старший врач по спортивной медицине ФГБУ НЦСМ ФМБА России, Председатель комитета по медицине и антидопингу ФЛГР, старший врач ФЛГР, Член комитета по медицине Международной федерации лыжных видов спорта (FIS)

Республиканский центр охраны здоровья семьи и репродукции
Бесплодие ЭКО Репродукция

DOLBIKFIT
🫀Этот канал — про здоровье,питание и тренировки,которые не забирают всю жизнь Чем могу помочь👉🏻 @dolbikfit_services Связаться : @maria_nine

Психиатрическая больница (ПБ)
Эстетика психиатрии. Обратная связь: @PsyPbBot Вк: https://vk.com/psichiatricheskaya


«ПРОСТО О КОЖНОМ» с Александром Фроловым
Врач-косметолог @cosmetolog_frolov - заведующий отделением эстетической медицины и косметологии Major Beauty. Тренер. Спикер. Наставник.

Записки Cat_
🔥5 лет в NL, 1000+ похудевших, доход 400К/мес — научу и тебя 💎Худеем на 5-15кг и делаем от 100К без диет и гантелей 🎁Пиши ХОЧУ→ забирай план работы

CONCUBINE
Создаю моду на психическое здоровье! 😌. Канал с качественной , проверенной информацией в области психиатрии 👌.#психиатрия Написать в личные сообщения @concubinelife https://instagram.com/concubine Ссылка на канал https://t.me/concubinedoc

Челлендж Трансформация
Купим ваш лишний вес - дорого 🫰 Результаты участников: @otz_challenge Администрация: @chelleng_zabota

Говори
Актёрско-хореографическая платформа современного танца 📍 Москва Создай свой танец вместе с @octuliya

Невролог - Школа головной боли Анаит Шагбазян
Невролог. Психолог. Майндфулнесс-тренер. Основатель Школы головной боли. Тут достоверная информация головных болях и как с ними справиться Для связи - https://t.me/anaitsha Бот Школы головной боли - https://mnlp.cc/mi
